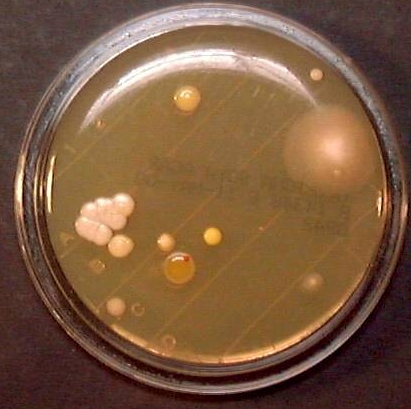

LABORATORIOS LOPEZ VALERO
Laboratorios López Valero SL viene desarrollando, desde el año 1980, funciones de producción y de servicios, en:
* la fabricación de productos químicos y sus sistemas de aplicación para la limpieza y desinfección, en el sector de manipulación y elaboración en industria alimentaria y otros sectores, tanto para tratamiento de superficies como para la higiene del personal manipulador
* la colaboración con sus clientes en el desarrollo e implantación de los sistemas de puntos críticos APPCC's (análisis de peligros y puntos críticos de control)
* la formación teórica y práctica del personal laboral en el ámbito de la manipulación alimentaria. Cursos de formación inicial y cursos de formación continua
* la realización de análisis microbiológicos de superficie y evaluación de situación, aplicados como soporte de formación, control de limpieza y desinfección y establecimiento de objetivos de mejora
* estas actividades, en la mayoría de los casos, se efectúan de una forma integrada y global, lo que implica una productividad, rentabilidad y aprovechamiento óptimos

|
Noticias |

DOCUMENTOS PUBLICADOS POR EL MINISTERIO DE SANIDAD CON RECOMENDACIONES FRENTE AL CORONAVIRUS COVID-19
DOCUMENTOS PUBLICADOS POR EL MINISTERIO DE SANIDAD CON RECOMENDACIONES FRENTE AL CORONAVIRUS COVID-19
 Colaboración IVACE / Laboratorios López Valero S.L
Colaboración IVACE / Laboratorios López Valero S.L
 &
&  Casos de Listeria, Salmonella y otros microorganismos patógenos
Casos de Listeria, Salmonella y otros microorganismos patógenos
 Los fabricantes empezaron a utilizar el miedo a oler mal para vender sus productos
Los fabricantes empezaron a utilizar el miedo a oler mal para vender sus productos
 http://www.consumer.es/web/es/alimentacion/aprender_a_comer_bien/alimentos_a_debate/2015/02/09/221461.php
http://www.consumer.es/web/es/alimentacion/aprender_a_comer_bien/alimentos_a_debate/2015/02/09/221461.php
 http://www.elconfidencial.com/alma-corazon-vida/2014-10-03/los-secadores-de-mano-de-los-lavabos-favorecen-la-contaminacion-bacteriana_223859/
http://www.elconfidencial.com/alma-corazon-vida/2014-10-03/los-secadores-de-mano-de-los-lavabos-favorecen-la-contaminacion-bacteriana_223859/
 http://www.elconfidencial.com/alma-corazon-vida/2014-12-18/lo-estas-haciendo-mal-los-errores-que-cometes-al-lavarte-las-manos_591061/
http://www.elconfidencial.com/alma-corazon-vida/2014-12-18/lo-estas-haciendo-mal-los-errores-que-cometes-al-lavarte-las-manos_591061/
 Lavado de manos, clave para la seguridad alimentaria: vídeo y artículo de Consumer sobre la higiene de manos
Lavado de manos, clave para la seguridad alimentaria: vídeo y artículo de Consumer sobre la higiene de manos
 La Generalitat Valenciana ha publicado en su página Web dos vídeos concernientes al uso de los plaguicidas y biocidas. En su día nos pidieron permiso para filmar en nuestras in
La Generalitat Valenciana ha publicado en su página Web dos vídeos concernientes al uso de los plaguicidas y biocidas. En su día nos pidieron permiso para filmar en nuestras in  http://www.aemps.gob.es/informa/notasInformativas/cosmeticosHigiene/2012/docs/COS_06_2012.pdf
http://www.aemps.gob.es/informa/notasInformativas/cosmeticosHigiene/2012/docs/COS_06_2012.pdf
 Enlace
Infografía de Eroski Consumer sobre las bacterias, su entorno y su prevención.
Sobresaliente, como siempre
Enlace
Infografía de Eroski Consumer sobre las bacterias, su entorno y su prevención.
Sobresaliente, como siempre
 Enlace
El espacio.
Enlace
El espacio.
 Enlace
Impactantes imágenes del mensaje mas repetido y menos tenido en cuenta
Enlace
Impactantes imágenes del mensaje mas repetido y menos tenido en cuenta
 Dicen que el pescado es caro
Dicen que el pescado es caro
 Comer con seguridad en la oficina. Consejos para mejorar la seguridad alimentaria en estas circunstancias. Vídeo de la página Consumer del Grupo Eroski.
Comer con seguridad en la oficina. Consejos para mejorar la seguridad alimentaria en estas circunstancias. Vídeo de la página Consumer del Grupo Eroski.
 Feria Hygienalia Pulire. Les esperamos en nuestro stand ubicado en 7B037
Novedades de Laboratorios López Valero presentadas en la Feria
http://www.hygienalia-pulire.com/es/Expositores/62
Feria Hygienalia Pulire. Les esperamos en nuestro stand ubicado en 7B037
Novedades de Laboratorios López Valero presentadas en la Feria
http://www.hygienalia-pulire.com/es/Expositores/62  Imágenes preciosas del agua que nos rodea y su ciclo
Música: Kitaro - Matsuri
Imágenes preciosas del agua que nos rodea y su ciclo
Música: Kitaro - Matsuri
 Segun un estudio de la Universidad de Valencia el 43% de los zumos de naranja exprimidos ofrecidos en bares y restaurantes incorporan microorganismos
Segun un estudio de la Universidad de Valencia el 43% de los zumos de naranja exprimidos ofrecidos en bares y restaurantes incorporan microorganismos
 Lluvia de pájaros en el océano
http://www.youtube.com/watch?v=-qQDaZ4BOjc&feature=related
Lluvia de pájaros en el océano
http://www.youtube.com/watch?v=-qQDaZ4BOjc&feature=related
 Es una obligación
http://www.youtube.com/watch?v=TnnMqU-u5EQ
Es una obligación
http://www.youtube.com/watch?v=TnnMqU-u5EQ
 2011, un año marcado por dos graves alertas...
El año 2011 ha sido, en materia de seguridad alimentaria, el de la contaminación radiactiva en Japón y el E.
2011, un año marcado por dos graves alertas...
El año 2011 ha sido, en materia de seguridad alimentaria, el de la contaminación radiactiva en Japón y el E.  Isabelita Plumero Vivales, del Instituto E.M de La Cuesta del Rato, ha sido la ganadora del concurso de febrero con su composición afotográfica.
Enhorabuena a la niña, bueno,
Isabelita Plumero Vivales, del Instituto E.M de La Cuesta del Rato, ha sido la ganadora del concurso de febrero con su composición afotográfica.
Enhorabuena a la niña, bueno, 